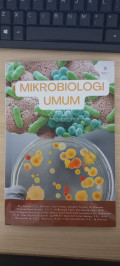

Koleksi
Advanced Search

Hasil Pencarian
Ditemukan 391 dari pencarian Anda melalui kata kunci: Subject : "Biologi"
Saat ini anda berada pada halaman 7 dari total 8 halaman
Permintaan membutuhkan 0.06298 detik untuk selesai
Informasi
Akses Katalog Publik Daring - Gunakan fasilitas pencarian untuk mempercepat penemuan data katalog